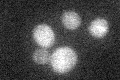
YGR184C
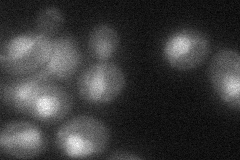
YGR184C
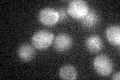
YGR184C

View description
E3 ubiquitin ligase (N-recognin), forms heterodimer with Rad6p to ubiquitinate substrates in the N-end rule pathway; regulates peptide transport via Cup9p ubiquitination; mutation in human UBR1 causes Johansson-Blizzard Syndrome (JBS)
Localization:
Intensity:
Fold change:
Significance:
-
C’ GFP library in SD
below threshold14.83 -
N' NOP1pr-GFP in SD

nucleus103.876 -
N' TEF2pr-mCherry in SD

nucleus,nucleolus106.419 -
N' NATIVEpr-GFP in SD

nucleus20.8159 -
N' TEF2pr-VC and Cyto-VN in SD
nucleus39.9458 -
C’ GFP library in SD+DTT

cytosol15.911.07No -
C’ GFP library in SD+H2O2
cytosol19.361.3No -
C’ GFP library in Starvation Media

cytosol16.731.12No -
C’ GFP library on the background of Pup2-DaMP

below threshold -
C’ GFP library on the background of CCT mutant

below threshold17.2321.16155No
